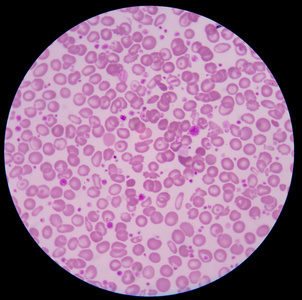
医学背景红血细胞照片

人血细胞显微镜图

显微镜下的人类血细胞
图片尺寸1200x900
(图:shutterstock)▼显微镜下的红细胞凝集,透着点诡异1900年,奥地利
图片尺寸3024x3024
显微镜下的人血涂片,白细胞在视野中央
图片尺寸960x1280
人血教学玻片
图片尺寸1000x2000
显微镜下的世界 #看血细胞 - 抖音
图片尺寸1440x2672
1000倍显微镜下的人体血细胞
图片尺寸1200x826
显微镜下的血细胞
图片尺寸349x336
如图是"用显微镜观察人血的永久涂片"实验中在显微镜下观察到的血细胞
图片尺寸587x472
实验室显微镜用细胞 血细胞白细胞盖玻片 生物血盖片 血球计数板
图片尺寸800x800
血细胞显微镜下形态
图片尺寸1004x654
第130期重庆市检验质控中心"金显微镜"形态学培训
图片尺寸1136x1542
医学背景红血细胞照片
图片尺寸302x300
如图是用显微镜观察人血的永久涂片实验中在显微镜下观察到的血细胞请
图片尺寸179x149
理化生 《人体内物质的运输》复习课件答案ppt 显微镜下血细胞的形态
图片尺寸1080x810
医疗血液细胞.
图片尺寸1100x1100
显微镜下观察红细胞&白细胞
图片尺寸640x569
生物显微镜标本切片红细胞白细胞显像清晰易观察显微玻片 人血涂片瑞
图片尺寸350x350
如图是显微镜下看到的血细胞.
图片尺寸338x150
人血涂片(400×)①红细胞 ②嗜酸性粒细胞 ③嗜中性粒细胞 ④单核细胞
图片尺寸455x289
在医院检验科工作会是怎样的体验?
图片尺寸720x533